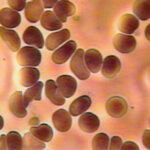

やめるんだ!走らなくなっちゃう!
リトルカブのドリブンスプロケットを39T→36Tに交換することにしました。前の16Tで充分だったけれど、16-36Tというハイギヤ仕様だとどうなってしまうのかという興味本位でついうっかり。オイル交換で垂れ流しながら交換開始!以下個人メモです。

まずマフラーがくっついているとアクスルシャフトが抜けないので取り外し。ナット3つだけで外せました。超簡単。

チェーンケースを外す。

今回交換予定のドリブンスプロケット。

とりあえずホイールにくっついているものを外す。

まずブレーキの遊び調整のそれがしを外す。ブレーキロッドだっけ何だっけ。

割りピンを真っ直ぐにして抜いてナット外して、トルクリンクとブレーキパッドを分離。

アクスルナットとかを全部外す。

アクスルシャフトを抜く。ホイールが外れるようになる。

ホイールを引っ張り出す隙間が無いのでドリブンスプロケまわりと分離でなんとかOK。

待望のドリブンスプロケットを交換。ナットを4つ外すだけで交換できるけれどこれが固い!めちゃくちゃ固い!556吹いても固い!ホイールにはめてもかなり力が必要でなかなか恐ろしかった。長いスパナがあれば楽だったかも。
交換が終わったら逆順で組み直してチェーン調整して油注して終了の2時間ぐらい。どちらかというとチェーン調整がやたら時間かかってそう。
16-36T所感はドライブスプロケットを16Tにした時点でヘロヘロだったので、その時よりあまり変化は感じない感じ。うるさいぐらいまで回して1速は0-30km/h。2速は20-50km/h。3速は35km/h~といったところで1速と2速が39Tの時より気持ち良くなった。3速はもう完璧に加速後の巡航用。バランスとしてはやはり15-39Tが丁度良さそう。50ccはどこまでいっても50ccということで。
試した中で個人的な好みは 15-39>16-36>16-39=14-39(ノーマル)
通勤で使っている道の往復は普通にできたのでしばらくこれでいってみようと思います。
ギャー、手袋していたのに人差し指から流血…!

コメント